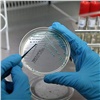

В молоке с красноярских ферм нашли превышение допустимых показателей по микроорганизмам и антибиотикам.
Специалисты Управления Россельхознадзора по Красноярскому краю рассказали об итогах мониторинга качества и безопасности молока в регионе. По данным пресс-службы ведомства, за девять месяцев этого года было отобрано 157 проб молока и молочной продукции, произведенных на молочно-товарных фермах края.
По результатам лабораторных исследований в 25 случаях установлено несоответствие этих продуктов требованиям безопасности по микробиологическим показателям (количеству мезофильных аэробных и факультативно-анаэробных микроорганизмов, дрожжам, плесени, соматическим клеткам) и антибиотикам тетрациклиновой группы.
По всем случаям выпуска на рынок не соответствующей требованиям продукции управление совместно с краевой Службой по ветеринарному надзору приняло в отношении предприятий меры для устранения причин нарушений. Так, на 18 предприятиях вводился режим усиленного лабораторного контроля, который по состоянию на 1 октября на 9 предприятиях снят по результатам отрицательных лабораторных исследований.